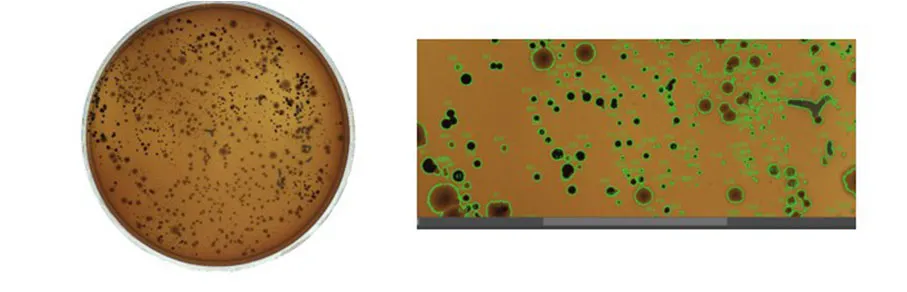

Key Features:

- Advanced detection through optimized illumination: The proper selection of illumination enhances specific visual characteristics of different bacterial types, enabling accurate localization.
- Automatic classification using artificial intelligence: AI algorithms analyze the images of each microorganism and classify them based on their visual appearance by type, ensuring consistent and reliable results.
- Accurate and traceable counting: Once classified, CCM performs the precise count of each bacterial type, generating clear and comprehensive data for subsequent analysis.
- Flexible integration into laboratory environments: CCM easily adapts to existing workflows, improving efficiency without the need for complex structural changes.
How CCM Works:
The CCM solution combines advanced vision hardware with machine learning algorithms to identify microscopic visual patterns characteristic of each type of bacteria. Adjustable illumination highlights specific details of each cell, while AI algorithms automatically classify and count the microorganisms. This approach not only accelerates the process but also ensures a high level of accuracy and repeatability.
With CCM, laboratories can increase productivity, reduce variability in analyses, and obtain more detailed information to support decision-making, ensuring superior quality control and reliable results in every assay.